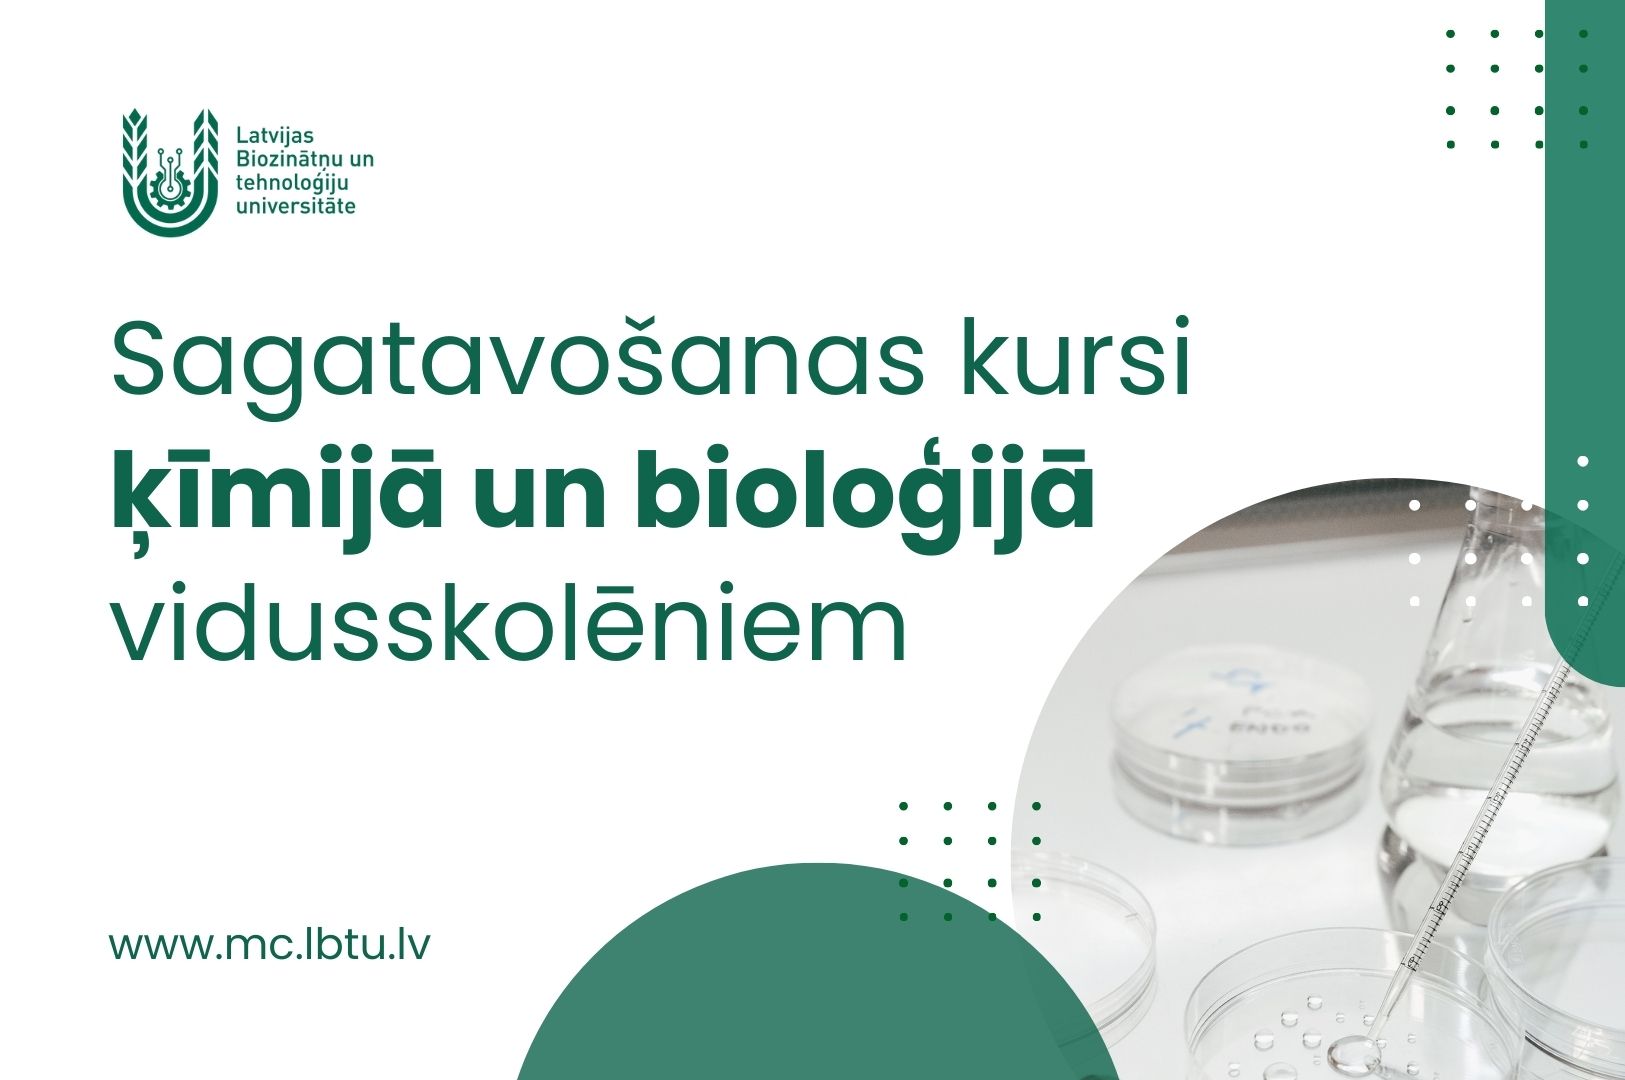
LBTU

LBTU Mūžizglītības centrs Jelgavā piedāvā sagatavošanas kursus ķīmijā un bioloģijā vidusskolēniem
Lai palīdzētu vidusskolas izlaidumu klašu skolēniem un vidējo izglītību ieguvušajiem sagatavoties studijām augstākās izglītības iestādēs, Latvijas Biozinātņu un tehnoloģiju universitātes (LBTU) Mūžizglītības centrs Jelgavā no 24. janvāra piedāvā kursus ķīmijā un bioloģijā – katru 60 stundu apjomā.
Ķīmijas un bioloģijas priekšmetu apguve visbiežāk ir viens no lielākajiem izaicinājumiem skolēniem, jo dabas un ķīmisko procesu iepazīšana un izpratne nav viegla. Taču tieši šīs zināšanas paver plašas iespējas studijām biozinātnēs un inženierzinātnēs augstākās izglītības līmenī, kurās sagatavotie speciālisti ir pieprasīti darba tirgū.
Kursu noslēgumā LBTU Mūžizglītības centrs piedāvā kārtot noslēguma pārbaudījumu, kurā iegūtā atzīme tiek ņemta vērā, iesniedzot dokumentus uzņemšanai kādā no LBTU studiju programmām.
Kursi sāksies 24. janvārī un turpmāk notiks sestdienās (četras akadēmiskās stundas, vienas akadēmiskās stundas laiks ir 45 minūtes). Ķīmijas kursi plānoti no plkst. 10.00 līdz plkst. 13.00, bet bioloģija sāksies plkst. 13.30 un ilgs līdz plkst. 16.30. Maksa par viena kursa apguvi 60 stundu apjomā ir 230 eiro (maksājumu iespējams dalīt divās daļās). Daļa no kursiem notiks attālināti.
Pieteikšanās ķīmijas kursiem iespējama, izmantojot šo saiti.
Pieteikšanās bioloģijas kursiem iespējama, izmantojot šo saiti.
Detalizēta informācija un pieteikšanās: LBTU Mūžizglītības centrs, Lielā iela 2 (163. telpa), tālr.: 63005715, 29171112, e-pasts: antra.berzina@lbtu.lv.
LBTU ir viena no vadošajām Baltijas jūras reģiona zinātnes un tehnoloģiju universitātēm ar specializāciju dabas resursu ilgtspējīgā izmantošanā sabiedrības dzīves kvalitātes paaugstināšanai. Tā piedāvā studijas plašā nozaru lokā: informācijas tehnoloģijās, inženierzinātnēs, ekonomikā, socioloģijā, menedžmentā, ainavu arhitektūrā, pārtikas tehnoloģijā, mežsaimniecībā, ģeoinformātikā un tālizpētē, biosistēmu mašinērijā un tehnoloģijās, zemes ierīcībā, enerģētikā, veterinārmedicīnā, lauksaimniecībā un citās jomās. Ar visām LBTU studiju programmu piedāvājumu iepazīties var mūsu mājaslapā.